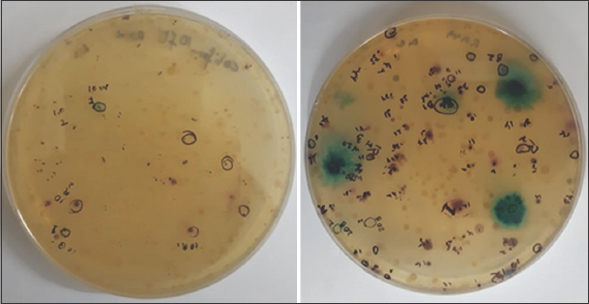

1. INTRODUCTION
Groundwater contamination by geogenic arsenic (As) is a major global health issue. As, the most prevalent toxic metalloid of the environment had emerged as a potential threat through geogenic contamination in the lower Gangetic plains of India [1] and Bangladesh [2]. As contaminated water obtained (at a concentration of 2–100 ppm) from subsurface or deep aquifers and its usage for drinking, cooking, and irrigation is a significant cause of As poisoning to nearly 40 million people in West Bengal, India. In sediments, As remains sorbed onto hydrated ferric oxides, phyllosilicates, sulfides, and other mineralogical hosts [3]. More than fifty As species have been identified, out of which inorganic species of trivalent arsenite (AsIII) and pentavalent arsenate (AsV) are most significant from the point of view of eco-geochemical studies. The toxicity of As and its mobilization from sediment to groundwater depends on its redox state. Among the inorganic As species, arsenite and arsenate are considered to be more toxic [4].
However, many bacteria can tolerate As well above the toxicity limit (10 mg/L), as stated by the WHO. Microbes interact differentially with different species of As, such as changing their oxidation state, preventing uptake, effluxing them, and finally using them as electron acceptors. The different oxidation state of As also varies with respect to their degree of affinity towards sediment minerals, AsV is relatively more bound and AsIII being more mobile [5]. The release of As from soil and sediments has often been related to metal-reducing bacteria. Under anaerobic conditions as prevalent in deep surface sediments, dissimilatory arsenate-respiring prokaryotes are the predominating arsenate-reducing microbial members. They use various organic (e.g., lactate, acetate, formate, and aromatics) or inorganic (hydrogen and sulfide) electron donors and As(V) as an electron acceptor, resulting in the production and release of As(III) into water [6].
However, in subsurface sediments of lesser depth, microbial As cycling and their mobilization are rarely studied in anaerobic environments. The microbial population in this region might be more affected by anthropogenic activities on the surface. Compared to As metabolizing populations in deeper aquifer sediments, microbial communities from lesser depth might differentially respond to As stress. Such difference might be due to the difference in composition and type of As-resistant microbial community at various soil depths. Several reports of aquifer sediments being reservoirs and better survival habitats for coliforms have been previously reported, but their role in As mobilization in sediment is scarcely reported [7]. Coliforms are indicators of fecal contamination and anthropogenic interference into the natural geogenic system and hence can be regulated [8]. Establishing their role in As mobilization would encourage the correlation of hygienic/sanitary conditions to groundwater As contamination. Based on the fact mentioned above, we attempted to determine the abundance of the As resistant total and coliform count under an aerobic and anaerobic condition followed by isolation and characterization of As resistant fecal non-fecal coliforms.
2. MATERIALS AND METHODS
2.1. Site of Sediment Sample Collection
Aquifer sediment samples were collected from the depths of 10, 20,40, 80, and 100 feet at the site (23.1128° N, 88.5318° E), Chakdah, Nadia, West Bengal, India [Figure 1]. The sediments were preserved and handled in the anaerobic glove box (N2 gas phase) to maintain an oxygen-free environment. For this study, samples of depth 10 and 20 feet were chosen to observe the presence of coliforms that might have seeped from pit latrines or open defecation. Total As resistant bacterial count under aerobic and anaerobic condition was recovered on SeFR1 media amended with arsenic [9].
 | Figure 1: Map of Sampling site, Chakdah Block, Nadia district, West Bengal, India. [Click here to view] |
2.2. Enrichment, Isolation and Characterization of As Resistant Coliforms
Microcosms were developed in sealed glass vials by inoculating sediment samples in Hi-Crome coliform chromogenic broth [10]. The The entire preparation was carried out in an anaerobic glove box (N2 gas phase), and each of the vials was injected with pure nitrogen before sealing. The vials were inoculated at 37°C for 48 h till the color of the media changed. Next, 50 ml of enriched broth was made to spread on the same media agar plates and incubated under anaerobic conditions. Plates were appropriately sealed after maintaining nitrogen head in the plates. The plates were subsequently incubated for 24 h to obtain differential colored colonies [Figure 2]. From enrichment cultures obtained from two different depths, 5 colonies (2 colorless, two red, and one blue) were randomly selected for further study. Finally, all the isolated were maintained under the anaerobic condition on the same media amended with 370 ppm (5 mM) As equivalence arsenate.
| Figure 2: Blue and Red Colonies on HiCrome coliform chromogenic agar. [Click here to view] |
2.3. Molecular Characterization of Isolates
2.3.1. Isolation of genomic DNA from isolates
Genomic DNA was isolated from each of the five coliform isolates by the sodium dodecyl sulfate-proteinase K-cetyltrimethylammonium bromide (CTAB) method [11,12]. Cells from overnight cultures were suspended in TE buffer and lysed with SDS and lysozyme for 1 h at 37°C, followed by treatment with CTAB-NaCl. From the lysate, DNA was extracted in the aqueous phase by chloroform: isoamyl alcohol (24:1) and phenol [TrisHCl (pH 8.0) saturated phenol]: chloroform: isoamyl alcohol (25:24:1) based extraction in succession. DNA was precipitated using isopropanol, washed using 70% ethanol, air-dried, and resuspended in TE buffer. The purity of the DNA samples was determined using spectrophotometry (OD260/280).
2.3.2. PCR amplification using 16S rDNA specific primers
A 950bp portion of the 16S rDNA gene from the isolated strain was amplified by the polymerase chain reaction (PCR). The PCR mix consisted of dNTPs at 200 mM each, 0.25 mM of each primer, 2.5 mM MgCl2, 1× PCR buffer, and 2U of Taq DNA polymerase (Promega, USA). Approximately 20–50 ng of genomic DNA from each isolate was used per 50 ml PCR reaction, respectively. Amplification was carried out using forward primer 515F (5’–3’) GTGCCAGCAGCCGCGGTAA, and the reverse primer 1492R was (5’–3’) TACGGYTACCTTGTTACGACTT (Y= C/T) [13].
2.3.3. Sequencing of the amplicons and BLAST analysis
The amplified and gel-eluted PCR fragments of the above amplicons were sequenced in ABI 3100 Genetic Analyzer with primer “515F.” The sequencing reaction was performed by using the Big Dye terminator cycle sequencing Kit V3.1 (Applied Biosystems, Foster City, USA) following the manufacturer’s protocol. The partial 16S rDNA sequences of the isolated strains were compared with those available in the public databases. In addition, the BLAST algorithm compared nucleotide sequences to those in the GenBank database to identify sequences with a high degree of similarity.
3. RESULTS AND DISCUSSION
Total As resistant bacterial count obtained under aerobic incubation condition on arsenate amended SeFR1 media exhibited slight variation with variation in-depth, while recovery of anaerobic population exhibited significant increase with the increase in depth [Figure 3]. Viable bacterial population count (in gDW-1) was reported to vary from ∼108 at the surface to nearly 102 at a depth of 140 feet in Buried valley aquifer sediments [14]. In another study, the increase in depth from 1.2 to 4.9 m and the aerobic bacterial population count decreased from 105 to 103 in sediment samples. Anaerobic population count (103 to <102) decreased 100-fold lower than aerobic counts with the increase in depth [15], a pattern contrary to our findings. Similar to our study, the increase in recovery of anaerobic bacteria with the increase in depth was previously reported [16]. The availability of oxygen in soil or sediment pore space governs the abundance of physiological types of microbes [17].
 | Figure 3: Arsenic Resistant Bacterial Count. (Standard deviation mentioned above each bar). [Click here to view] |
The surficial clay layers in the shallow aquifers of the Bengal basin restrict the inflow of oxygen in the aquifers, thereby generating strong reducing or anaerobic conditions at greater depths [18]. Such conditions might be responsible for the prevalence of arsenate tolerant anaerobic bacteria at greater depths. Anoxic environments favor the microbial reduction of bound As (V) to mobile As (III), leading to groundwater pollution [19]. Coliforms are facultative anaerobic bacteria, which can thrive and grow under anaerobic conditions. As stated earlier, the characteristics geological features of Bengal basins are responsible for the formation of conditions conducive to the coliforms in general and fecal coliforms like Escherichia coli in particular [20]. Prevalence of E. coli, an indicator of fecal pollution, and other coliforms in aquifer sediments have often been reported [21,22]. A major source of such pollution in Bengal Delta Plain could be the prevalence of pit latrines in rural regions, from where coliforms could contaminate aquifer systems by physical advection, hydrodynamic dispersion, or microbe decay [23]. HiCrome coliform chromogenic agar (HiMedia Laboratories Pvt. Ltd., Mumbai, India) has been successfully used to differentially determine the distribution of fecal and non-fecal coliforms in water, food, and environmental samples [24].
In a microbial profiling study along depths of an As impacted aquifer in Bangladesh, Gammaproteobacteria, which includes coliforms, exhibited maximal abundance in all depths, with a slight increase at shallower depths followed by a gradual decrease at greater depths [25]. Coliforms are a group of facultative anaerobes that possess mechanisms for adapting to various oxygen stress [26]. Fecal coliforms such as E. coli have often been used to indicate fecal pollution in As-contaminated aquifer ecosystems [27]. The count of arsenate-resistant E. coli increased at greater depths, indicating their prevalence at those depths [Figure 4].
 | Figure 4: (a) Coliform count under anaerobic condition; (b) Coliform count under aerobic condition (Error bar represents standard deviation). [Click here to view] |
In our study, incubation under anaerobic conditions exhibited a higher recovery of coliforms which corroborated with previous findings [28]. Though a negative correlation between the degree of As contamination and E. coli detection frequency in aquifer environments has been reported, amongst the possible reasons As toxicity is being ruled out, taking into consideration their diverse detoxifications pathways [29]. arsC gene that encodes for protein Arsenate reductase that contributes to arsenate tolerance in E. coli. As (V) is being uptaken into the cells, reduced to toxic and mobile As (III) and extruded out [30]. It defines the role of E. coli in As mobilization from sediments into groundwater. Prevalence of anaerobic conditions in Bengal delta plain subsurface aquifers could be a favorable condition for As mobilization by E. coli. Coliforms, fecal coliforms, and non-coliforms were differentially purified on arsenate amended HiCrome coliform chromogenic agar in this study. Two isolates obtained from the two red colonies are coded as R1 and R2, isolate obtained from the blue colony was coded as B1, and isolates obtained from the colorless colonies were coded as CL3 and CL4. Another strain that was obtained from a colony on the SeFr1 plate was coded as SeFr1. Successful amplification of 950 base pairs of the 16SrDNA was successfully carried out, and subsequent sequence-based BLAST-N analysis confirmed the findings [Table 1]. Enterobacter [31], Citrobacter [32], Escherichia [33], and Pseudomonas [34] has been previously reported to have As tolerant property. Recent study had reported prevalence of anoxic condition favors the prevalence and growth of facultative anaerobic As reducing bacteria in aquifer sediments which corroborated with our study [35].
Table 1: Molecular Characterization of isolates were as follows.
| Sample Code | Identification based on 16S rDNA sequence Analysis | NCBI 16S rDNA based accession number of the homologous strain | % Similarity |
|---|---|---|---|
| R1 | Enterobacter hormaechei strain SKB16 | MN658825.1 | 98.72 |
| R2 | Citrobacter sp. strain 3AMTO | MN651329.1 | 99 |
| B1 | Escherichia coli strain PP5 | MN754025.1 | 99 |
| CL3 | Pseudomonas aeruginosa strain PA-3 | KT266561.1 | 99 |
| CL4 | Pseudomonas aeruginosa isolate 9 | FJ907192.1 | 97.46 |
| SEFR Isolate | Pseudomonas stutzeri strain 1-4 | HQ285874.1 | 95.96 |
4. CONCLUSION
This was a preliminary study to analyze the presence and role of coliforms in As contaminated aquifer sediments. From our study, it could be concluded that As resistant microbial community in aquifer sediments varied with respect to their response to oxygen stress, aerobic population dominating at lesser depth and anaerobic population increased with the increase in depth. However, fecal coliforms were found to be more prevalent at greater depths, seepage from fecal dumpings like pit latrines might be a cause. The coliforms were characterized and those exhibiting features of fecal coliforms (the blue colony on HiCrome coliform chromogenic agar) were microscopically, biochemically, and molecularly confirmed to be 99% similar with E. coli strain PP5 (MN754025.1). However, their potentiality in mobilizing As is yet to be studied.
5. ACKNOWLEDGEMENT
The authors of this manuscript are grateful for the Infrastructural support provided by host institution, Vijaygarh Jyotish Ray College needs special mention.
6. AUTHORS’ CONTRIBUTIONS
All authors made substantial contributions to conception and design, acquisition of data, or analysis and interpretation of data; took part in drafting the article or revising it critically for important intellectual content; agreed to submit to the current journal; gave final approval of the version to be published; and agreed to be accountable for all aspects of the work. All the authors are eligible to be an author as per the International Committee of Medical Journal Editors (ICMJE) requirements/guidelines.
7. FUNDING
Financial support to Mr.Subhankar Barua (Senior Research Fellowship Vide CSIR File No: 08/645(0001)/2017-EMR-I) is acknowledged. Funding support from SERB-EMEQ (No.SB/EMEQ-105/2014) is also being acknowledged.
8. CONFLICTS OF INTEREST
The authors report no financial or any other conflicts of interest in this work.
9. ETHICAL APPROVALS
This study does not involve experiments on animals or human subjects.
10. DATA AVAILABILITY
The datasets generated during and/or analysed during the current study are available from the corresponding author on reasonable request.
11. PUBLISHER’S NOTE
This journal remains neutral with regard to jurisdictional claims in published institutional affiliation.
REFERENCES
1. Rahman MM, Sengupta MK, Ahamed S, Chowdhury UK, Hossain MA, Das B, et al. The magnitude of arsenic contamination in groundwater and its health effects to the inhabitants of the Jalangi one of the 85 arsenic affected blocks in West Bengal, India. Sci Total Environ 2005;338:189-200. [CrossRef]
2. Smith AH, Lingas EO, Rahman M. Contamination of drinking-water by arsenic in Bangladesh:A public health emergency. Bull World Health Organ 2000;78:1093-103.
3. Nickson RT, McArthur JM, Ravenscroft P, Burgess WG, Ahmed KM. Mechanism of arsenic release to groundwater, Bangladesh and West Bengal. Appl Geochem 2000;15:403-13. [CrossRef]
4. Welch AH, Oremland RS, Davis JA, Watkins SA. Arsenic in groundwater:A review of current knowledge and relation to the CALFED solution area with recommendations for needed research. San Francisco Estuary Watershed Sci 2006. Available from:http://repositories.cdlib.org/jmie/sfews/vol4/iss2/art2. [CrossRef]
5. Srivastava S. Understanding Bacteria. Berlin:Springer Science and Business Media;2003. 114. [CrossRef]
6. Oremland RS, Stolz JF. Arsenic, microbes and contaminated aquifers. Trends Microbiol 2005;13:45-9. [CrossRef]
7. Ghosh P, Das A, Majunder M, Kumar S. Arsenic mobilization process in shallow aquifer of Bengal delta plain:A field scale study to identify the role of coliform bacteria. Geochemistry 2020;15:372-82. [CrossRef]
8. BaudišováD. Evaluation of Escherichia coli as the main indicator of faecal pollution. Water Sci Technol 1997;35:333-6. [CrossRef]
9. Oremland RS, Blum JS, Culbertson CW, Visscher PT, Miller LG, Dowdle P, et al. Isolation, growth, and metabolism of an obligately anaerobic, selenate-respiring bacterium, strain SES-3. Appl Environ Microbiol 1994;60:3011-9. [CrossRef]
10. Lundborg CS, Diwan V, Pathak A, Purohit MR, Shah H, Sharma M, et al. Protocol:A 'One health'two year follow-up, mixed methods study on antibiotic resistance, focusing children under 5 and their environment in rural India. BMC Public Health 2015;15:1321. [CrossRef]
11. Foulds IV, Granacki A, Xiao C, Krull UJ, Castle A, Horgen, P. A. Quantification of microcystin-producing cyanobacteria and E. coli in water by 5′-nuclease PCR. J Appl Microbiol. 2002;93:825-34. [CrossRef]
12. Ausubel FM, Brent R, Kingston RE, Moore DD, Seidman JG, Smith JA, et al. Current Protocols in Molecular Biology. New York:John Wiley and Sons;2003. 241-42.
13. Ghosh A, Maity B, Chakrabarti K, Chattopadhyay D. Bacterial diversity of East Calcutta Wet Land Area:Possible identification of potential bacterial population for different biotechnological uses. Microb Ecol 2007;54:452-9. [CrossRef]
14. Sinclair JL, Randtke SJ, Denne JE, Hathaway LR, Ghiorse WC. Survey of microbial populations in buried-valley aquifer sediments from northeastern Kansas. Groundwater 1990;28:369-77. [CrossRef]
15. Balkwill DL, Ghiorse WC. Characterization of subsurface bacteria associated with two shallow aquifers in Oklahoma. Appl Environ Microbiol 1985;50:580-8. [CrossRef]
16. Van Beelen P, Fleuren-KemiläAK. Enumeration of anaerobic and oligotrophic bacteria in subsoils and sediments. J Contam Hydrol 1989;4:275-84. [CrossRef]
17. Bhattarai A, Bhattarai B, Pandey S. Variation of soil microbial population in different soil horizons. J Microbiol Exp 2015;2:75-8. [CrossRef]
18. Ravenscroft P, Burgess WG, Ahmed KM, Burren M, Perrin J. Arsenic in groundwater of the Bengal Basin, Bangladesh:Distribution, field relations, and hydrogeological setting. Hydrogeol J 2005;13:727-51. [CrossRef]
19. Dowdle PR, Laverman AM, Oremland RS. Bacterial dissimilatory reduction of arsenic (V) to arsenic (III) in anoxic sediments. Appl Environ Microbiol 1996;62:1664-9. [CrossRef]
20. Roslev P, Bjergbæk L, Hesselsoe M. Effect of oxygen on survival of faecal pollution indicators in drinking water. J Appl Microbiol 2004;96:938-45. [CrossRef]
21. Selvam S, Ravindaran AA, Rajamanickam M, Sridharan M. Microbial contamination in the sediments and groundwater of Tuticorin Corporation, South India using GIS. Int J Pharm Pharm Sci 2014;6:337-40.
22. Aydin A. The microbiological and physico-chemical quality of groundwater in West Thrace, Turkey. Pol J Environ Stud 2007;16:377-83.
23. Islam MS, Mahmud ZH, Islam MS, Saha GC, Zahid A, Ali AZ, et al. Safe distances between groundwater-based water wells and pit latrines at different hydrogeological conditions in the Ganges Atrai floodplains of Bangladesh. J Health Popul Nutr 2016;35:26. [CrossRef]
24. Purohit MR, Chandran S, Shah H, Diwan V, Tamhankar AJ, StålsbyLundborg C. Antibiotic resistance in an Indian rural community:A 'One-Health'observational study on commensal coliform from humans, animals, and water. Int J Environ Res Public Health 2017;14:386. [CrossRef]
25. Gnanaprakasam ET, Lloyd JR, Boothman C, Ahmed KM, Choudhury I, Bostick BC, et al. Microbial community structure and arsenic biogeochemistry in two arsenic-impacted aquifers in Bangladesh. MBio 2017;8:e01326-17. [CrossRef]
26. Shrivastava A, Ghosh D, Dash A, Bose S. Arsenic contamination in soil and sediment in India:Sources, effects, and remediation. Curr Pollut Rep 2015;1:35-46. [CrossRef]
27. Knappett PS, McKay LD, Layton A, Williams DE, Alam MJ, Huq MR, et al. Implications of fecal bacteria input from latrine-polluted ponds for wells in sandy aquifers. Environ Sci Technol 2012;46:1361-70. [CrossRef]
28. Tandon P, Chhibber S, Reed HR. Inactivation of Escherichia coli and coliform bacteria in traditional brass and earthernware water storage vessels. Antonie Van Leeuwenhoek 2005;88:35-48. [CrossRef]
29. van Geen A, Ahmed KM, Akita Y, Alam J, Culligan PJ, Emch M, et al. Fecal contamination of shallow tubewells in Bangladesh inversely related to arsenic. Environ Sci Technol 2011;45:1199-205. [CrossRef]
30. Mukhopadhyay R, Rosen BP. Arsenate reductases in prokaryotes and eukaryotes. Environ Health Perspect 2002;110 Suppl 5:745-8. [CrossRef]
31. Nie L, Shah S, Rashid A, Burd GI, Dixon DG, Glick BR. Phytoremediation of arsenate contaminated soil by transgenic canola and the plant growth-promoting bacterium Enterobacter cloacae CAL2. Plant Physiol Biochem 2002;40:355-61. [CrossRef]
32. Shakoori FR, Aziz I, Rehman A, Shakoori AR. Isolation and characterization of arsenic reducing bacteria from industrial effluents and their potential use in bioremediation of wastewater. Pak J Zool 2010;42:331-8.
33. Hedges RW, Baumberg S. Resistance to arsenic compounds conferred by a plasmid transmissible between strains of Escherichia coli. J Bacteriol 1973;115:459. [CrossRef]
34. Aksornchu P, Prasertsan P, Sobhon V. Isolation of arsenic-tolerant bacteria from arsenic-contaminated soil. Songklanakarin J Sci Technol 2008;30 Suppl 1:95-102.
35. Sathe SS, Goswami L, Mahanta C. Arsenic reduction and mobilization cycle via microbial activities prevailing in the Holocene aquifers of Brahmaputra flood plain. Ground Sustain Dev 2021;13:100578. [CrossRef]